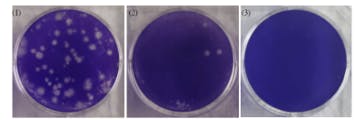

OZOFRESH CARE(NATURESETシリーズ)は、外部の第三者試験機関による正式な殺菌効力試験を受け複数のエビデンスがあります。
商品ページでは主に「ペットによる安全性(動物実験)」のエビデンスをご紹介していますが、今回の活動報告 Vol.4 では、“どれだけ多くの細菌に対して効果を検証しているか” という点に焦点を当ててお伝えします。
■ 合計8種類の細菌で正式に効果を検証
第三者機関の試験(報告書 No. N2203343-001)では、以下 8種類の細菌 を対象に殺菌性能が評価されています。
一般細菌
大腸菌
サルモネラ菌
緑膿菌
セレウス菌
黄色ブドウ球菌
腸炎ビブリオ菌
モラクセラ菌
これらは、日常生活やペットまわりで問題になりやすい“生活菌”を広くカバーしており、総合的で信頼性の高い検証が行われています。
参考までに・・
他社の国内のオゾン水生成器においても、第三者期間での調査は 1〜3種類のみの検証が多く、輸入製品などでは、“自社製品の試験を行わず、公開論文のデータだけを引用している”相乗りエビデンスのケースが多く見受けられます。
OZOFRESH CARE は、第三者機関で8菌種の試験を正式に実施している点が大きな特徴です。
■ オゾン水は“濃度”が安全性を左右します!
一口にオゾン水といっても、生成される濃度は製品ごとに異なり、特にペットに使用する場合は 濃度が最重要ポイントになります。
市販の一部製品では、高出力の生成コアにより「5〜7ppm」の高濃度が作られてしまうことがあります。
しかし 5ppmは“強殺菌域”であり、器具消毒レベルの濃度です。
● 5ppmがペットの口腔ケアに不向きな理由
粘膜刺激のリスクが高い
犬・猫の口腔内で安全性を示すデータが存在しない
ペットの口腔ケアに適した濃度は 0.2〜1ppm とされています。
動物医療の実務でも、5ppmを直接口腔内に使う臨床例はありません。
ペットの口腔ケアに 5ppm(5mg/L)以上のオゾン水を使用することは絶対に避けてください。
なぜ5ppmが危険なのか
1. 粘膜刺激・炎症リスク
犬や猫の口内は人間よりデリケートです。5ppmの強い酸化力は、歯肉・舌・頬の粘膜に刺激を与え、炎症や亀裂を起こす可能性があります。
2. 飲み込む=器官に負担
ペットはうがいができないため、口腔ケアで使うと 必ず飲み込んでしまいます。高濃度オゾン水を飲む安全性データは存在せず危険です。
3. 獣医歯科の推奨濃度から完全に外れている
世界的な動物歯科・皮膚科の基準では口腔ケアは 0.2〜1ppm,それを超える濃度は“外用(皮膚)でも注意”という扱いです。
5ppmをペットの口腔に使う臨床データは存在しません。
■ OZOFRESH CARE は“口腔ケアに最適な濃度”
OZOFRESH CARE のオゾン水濃度は、
ボトル内:約 1ppm
スプレー噴霧時:約 0.5ppm
毎日のデンタルケア、口臭対策、口まわり・顔まわりのケアに最適な安全域(舐めても安全)な設計が重視されています。
また、国内特許を取得している Hyper-OZ(オゾン生成コア)は、最大濃度2ppm が限界に制御され、誤って高濃度になりすぎるような心配もありません。
大切な家族(幼児・ペット)にも安心して使える製品として、「適正濃度」と「第三者機関エビデンス」を両立している点がOZOFRESH CARE の強みです。
医学的エビデンスにもとづいた信頼性があります。
このHigh-Per OG技術は、コロナ禍の2021年7月に奈良県立医科大学医学部(微生物感染症学教室・矢野寿一教授)とメーカー(HBコーポレーション)の共同研究によって開発されました。
電解式オゾン水噴霧装置に搭載したHigh-Per OG(ハイパーオージー)技術により水道水から生成したオゾン水の新型コロナウイルス不活化実証
結果、口腔内に存在するウイルスや菌を不活化する効果も確認されています。
薬品無添加・水と酸素のみで生成されるため安全性も非常に高いのが特長です。
・試験方法
新型コロナウイルス液20μl をシャーレ上に塗抹し、生成した試験水を15cmの距離から噴霧し一定時間反応させた。
コントロールとして同量のミネラルウォーター(Volvic)を用意し、同様に反応させた。反応後、チオ硫酸ナトリウム⼊りSCDLP 培地で反応を停⽌した。
回収液を⽤いてウイルス感染価をプラーク法にて測定した。
減少率=(1-1/10対数減少値)×100%にて算出。
※本試験は、奈良県立医科大学のバイオセーフティレベル3(BSL3) の実験施設内において適切な病原体封じ込め措置のもとに実施したものであり、実使用環境における効果を示すものではありません。
・試験結果
結果は、15秒後に99.996%減少、60秒後に99.997%減少となり、ウイルスが減少したことが確認された。
本試験で使用したオゾン水は新型コロナウイルス(SARS-CoV-2) を不活化することが判明した。
オゾン濃度0.34 - 0.53 mg/Lにおけるウイルス不活性化効果と減少率


不活化効果(Mv) = log(Ct/C0) - log(Nt/N0)
= logCt/Nt
Ct : コントロール t 時間後の感染価
C0 : コントロール 0 時間後の感染価
Nt : 試験品 t 時間後の感染価N0 : 試験品 0 時間後の感染価
N0 : 試験品 0 時間後の感染価
プラーク法による感染価測定例(1:コントロール、2:15秒後、3:60秒後)
この度、High-Per OG技術を搭載した電解式オゾン水噴霧装置により生成したオゾン水は新型コロナウイルス(SARS-CoV-2)を不活化することが確認できました。
本試験の結果から、生成したオゾン水を物質表面に付着した新型コロナウイルスに噴霧することで、接触感染防止に有効であると期待されます。
オゾンは不安定な構造のため分解しやすく、細菌やウイルス等とすぐに結びつき、強い除菌力を発揮します。
それでいて、使用後は酸素に戻るので安全で環境にも優しいとされています。
アルコール製剤はアルコールに過敏の方は使用ができないなど使用上の制約があります。
同技術により生成されるオゾン水が新型コロナウイルスに対しての効果が確認できたことから、アルコール製剤の代替えとして、また、一般公衆衛生用途における安全性確保の選択肢として、広く活用できる可能性が示されたことに一定の意義があると考えております。
【ペットのいる環境でアルコール除菌が危険な理由】
アルコール除菌剤は、人にとっては便利でも、犬・猫などのペットにとっては“中毒のリスク”がある危険な成分です。
■ 1. アルコール中毒の危険性
ペットは、人間のようにアルコールを分解する酵素を十分に持っていません。
少量を舐めたり、気化したアルコールを吸い込んだだけでも、
嘔吐
下痢
ふらつき
意識低下
などの症状が出ることがあり、
重度の場合はアルコール中毒に至ることもあります。
■ 2. 皮膚からの経皮吸収リスク
犬や猫の皮膚は人間より薄くデリケートです。アルコール成分が皮膚から吸収され、体調不良を引き起こす可能性も否定できません。
■ 3. 舐めてしまう習性がある
ペットは、床・ソファ・ケージ・自分の手足など、日常的に“舐めて確認する”習性があります。
そのため、アルコールをスプレーした表面に残留した成分が口に入るリスクが非常に高いのです。
【オゾン水ならペットに安心】
OZOFRESH CARE のオゾン水は“水”がベースのため、ペットの体に触れても、舐めても、残留成分の心配がありません。
また、アルコールや漂白剤と異なり、革製品や布製品でもシミになりにくいのも大きなメリットです。

■ 公開:第三者機関による試験エビデンス
※試験報告書の転載・複製は禁止されています(活動報告内で画像として掲載する場合は“閲覧のみ”にてお願いします)


他社製のオゾン水スプレーでも、大腸菌など一部菌種に対する除菌効果が示されている製品がありますが、公開されている試験は 、1〜3種類ほどの細菌に限定されています。
一方、OZOFRESH CARE(NATURESET)は、 8種類の細菌を対象に、正式な試験法で総合的に評価されているという点で、より“広い範囲の菌に対して第三者検証を受けている製品”と言えます。
これにより、OZOFRESH CARE が「生活環境で遭遇しやすいさまざまな菌に対して、幅広く検証されているプロダクト」であることが確認されています。
参考として、他社の一般的なオゾン水スプレーでは1種類〜数種類の細菌で評価されているケースが多く、OZOFRESH CARE は より広い菌種に対して第三者機関での試験を行っている 点が特徴です。
最新研究のエビデンス紹介(2025年6月公開)
【研究背景】
近年、抗生物質が効かない「耐性菌」の拡大が大きな課題となっており、犬の皮膚トラブル(皮膚炎や膿皮症など)でも 「抗菌薬に頼らないケア」 の重要性が高まっています。
そこで注目されているのが、高い除菌力と安全性を併せ持ち、残留性がない「オゾン水」
ただし、これまで犬の皮膚バリア機能にどのような影響を与えるかについては、十分に検証されていませんでした。
【研究目的と方法】
本研究では、オゾン水の有用性を以下の2点から検証しました。
検証項目内容① 抗菌効果ビーグル犬4匹を対象に、オゾン水の除菌性能を評価② 皮膚バリアへの影響ビーグル犬6匹で、刺激・乾燥・バリア機能への影響を観察
【研究結果】
オゾン水は犬の皮膚に対し高い抗菌効果を示した
皮膚への刺激・炎症・乾燥・バリア機能の低下は一切確認されなかった
さらに、比較対象として行った実験では、
オゾン水は「0.05% 次亜塩素酸ナトリウム(漂白剤)」と同等の抗菌力を持つことが判明
【結論】
オゾン水は犬の皮膚に対して、
・ 高い抗菌力
・残留性のない安全性
・ 皮膚バリア機能を守るやさしさ
を兼ね備えた、安心して使用できる除菌ケアであることが証明されました。
【臨床的な意義】
この研究結果は、オゾフレッシュケアのオゾン水スプレー が皮膚トラブルを抱えるワンちゃんにも安心して使用できることを裏付ける重要なエビデンスとなります。
市販の除菌剤のように薬剤残留のリスクがなく、敏感肌や皮膚炎の子にも使用できる点は、飼い主さんにとって大きな安心材料です。
公開エビデンス(PubMed)犬の皮膚に対するオゾン水の効果と安全性(Matsuda et al., 2025, 岡山理科大学獣医学部)
私たちは今後も、“根拠のある製品づくり” を大切にしながら、ペットと飼い主さんに寄り添ったケア情報を、活動報告を通じて発信してまいります。
皆さまの応援が、私たちの大きな力になります。
今後ともどうぞよろしくお願いいたします。
活動報告 Vol.4
―― OZOFRESH CARE プロジェクトチーム――




